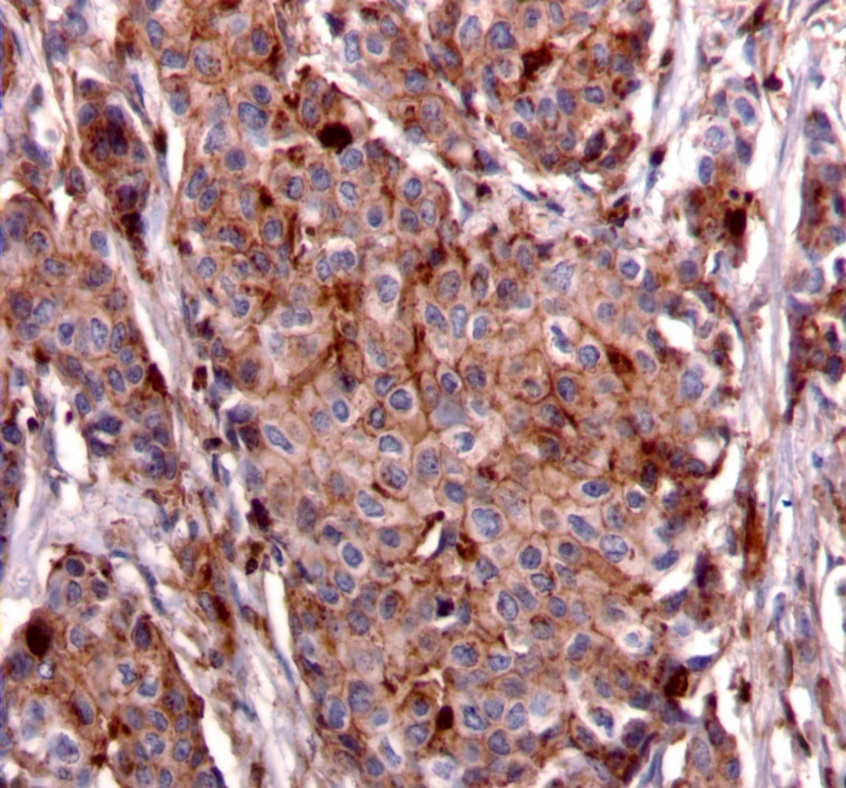

Correlation of Oncotype DX Recurrence Score with the Expression of Insulin Receptor Substrate Proteins in Estrogen Receptor + Breast Cancer
Abstract
Insulin receptor substrate (IRS) 1 and 2 are downstream signaling proteins that influence breast pathophysiology. IRS-1 promotes carcinoma cell proliferation; whereas IRS-2 regulates cell motility, invasion, and glycolysis. Our lab has shown that distinct cellular localization of IRS-2 also plays a role in carcinoma cell function. Oncotype DX (Genomic Health) (ODX) is a 21-gene expression profile used to classify carcinomas with low, intermediate, and high risk recurrence scores (RS). Our aim is to correlate expression and cellular localization of IRS proteins in breast carcinomas with their ODX RS. 97 breast carcinomas sent for ODX testing from 2006-2009 were collected and grouped according to their RS (low, intermediate or high). Immunohistochemistry for IRS-1/-2 was performed. Specific criteria were used to evaluate IRS staining patterns. Follow-up data, ranging from 3-6 years, was available. Statistical analysis was performed to correlate staining patterns of IRS-1/-2 with the three RS groups. IRS-1 staining, predominantly nuclear, did not significantly correlate with RS (P=.5645). IRS-2 expression patterns did show statistical significance amongst the three RS groups (P=.0371). Tumors with intermediate and low RS were more likely to exhibit punctate and diffuse cytoplasmic expression of IRS-2, and cell membrane expression was uncommon in this group. Expression and cellular localization of IRS proteins play an important role in breast cancer cell biology, and expression patterns for IRS-2 do demonstrate a significant correlation with ODX RS. Further studies are required to elucidate the significance of cellular localization of IRS-1/-2 proteins in breast carcinoma cells and their relationship to ODX scores.
Author Contributions
Academic Editor: Krzysztof Roszkowski, Department of Radiotherapy, the F. Lukaszczyk Oncology Center, Bydgoszcz, PL
Checked for plagiarism: Yes
Review by: Single-blind
Copyright © 2014 Vighnesh Walavalkar, et al.
This is an open-access article distributed under the terms of the Creative Commons Attribution License, which permits unrestricted use, distribution, and reproduction in any medium, provided the original author and source are credited.
Competing interests
The authors have declared that no competing interests exist.
Citation:
Introduction
The insulin receptor substrate (IRS) adaptor proteins (IRS-1 and IRS-2) are expressed relatively ubiquitously in human tissues and in many cancers.1 They act as signaling intermediates, downstream to multiple cytokine and growth factor receptors which are involved in the regulation of breast carcinoma cell function, including the insulin receptor (IR) and insulin-like growth factor receptors (IGF-1R).1,2,3,4,5,6,7,8 IRS-1 and IRS-2 are expressed in normal mammary epithelium, as well as in benign and malignant breast lesions.3 Despite considerable sequence and structural homology, IRS-1 and IRS-2 have been shown to serve divergent functions.2 IRS-1 expression is estrogen-dependent, promotes cellular proliferation but may inhibit disease progression; whereas progesterone-regulated IRS-2 upregulates glycolysis, promotes motility and invasion, and positively regulates tumor progression and metastasis.1,2,9,10,11,12.
A recent study from our lab examined IRS-1 and IRS-2 expression patterns in approximately 300 invasive breast tumors.13 Though most tumors exhibited nuclear expression of IRS-1 consistent with previous studies, expression of IRS-2 was variable; exhibiting diffuse cytoplasmic, punctate cytoplasmic, and cell membrane staining patterns.13 Multivariate analysis revealed a statistically significant decrease in overall survival associated with IRS-2 expression at the cell membrane.13 The progesterone receptor (PR) negative subset with cell membrane expression demonstrated significantly worse overall survival compared to all other subtypes.13 Though larger studies with longer follow-up are needed, we concluded that IRS-2 expression patterns in breast tumors, particularly in the setting of PR negativity, could be helpful in determining prognosis and guiding treatment.13
Tumor grade, receptor expression, nodal status, and clinical stage are currently used to determine prognosis and management of patients with breast cancer. However, genomic assays have become more widely used and accepted in recent years. One such assay is Oncotype DX (Genomic Health, Redwood City, CA), a 21-gene expression profile which assesses 5 groups of 16 cancer-related genes compared to 5 reference genes. It calculates a recurrence score (RS) from a complex mathematical formula based on the expression of genes from these groups (RS= 0.47x(HER2 Group score) - 0.34x(ER Group score) + 1.04x(Proliferation group score) + 0.10x(Invasion group score) + 0.05xCD68score - 0.08xGSTM1score - 0.07xBAG1score. (http://breast-cancer.oncotypedx.com, accessed January 9th, 2014)). The RS is classified as low, intermediate or high, which is used to predict the risk of recurrence in patients with estrogen receptor (ER) positive breast carcinomas; a subset for which the test has been well-validated.14,15 Studies have shown that patients with high RS tend to benefit more from chemotherapy.15 This was validated in a retrospective analysis using data from the National Surgical Adjuvant Breast and Bowel Project Clinical Trial Study B14 and B20.14,15 Oncotype DX testing is also discussed in the National Comprehensive Cancer Network guidelines for the treatment of ER+ breast cancer.16
Though the utility of genomic testing in the management of certain breast cancer patients has been well-validated, high cost is a major limitation. Studies have shown that routinely used parameters such as high mitotic rate and proliferation marker expression, as well as mathematical equations similar to those used by Oncotype DX involving hormone receptor status and human epidermal growth factor receptor 2 (HER2) expression, correlate well with Oncotype DX recurrence scores.17, 18, 19 The same may be applied to a variety of validated biomarkers which when used in combination may provide similar information by immunohistochemistry (IHC) alone at reduced cost. To our knowledge, the association between IRS protein expression in breast tumors and Oncotype DX recurrence scores has not yet been studied.
Materials and Methods
Tumor Sections
Formalin-fixed, paraffin-embedded tumor sections were obtained from the pathology department archives for all breast carcinomas sent for Oncotype DX testing from 2006-2009 during the course of routine care. In our institution Oncotype DX testing is performed on breast cancer samples based on the National Comprehensive Cancer Network (NCCN) Guidelines on ancillary testing in the United States14,15,16; or in some cases at the discretion of the attending oncologist, after review at a multidisciplinary tumor board meeting. Institutional Review Board (IRB) approval was obtained for this study. Complete data on tumor size, tumor grade, node status, and receptor status were available. For many patients, follow-up data on recurrence-free survival, overall survival (OS), metastases, and therapy were also available.
Immunohistochemistry
Immunohistochemically studies were performed on 5-um sections of formalin-fixed, paraffin-embedded tissue. Antigen retrieval was carried out with 0.01M citrate buffer at pH 6.0 for slides to be stained with IRS-1 and 0.001M EDTA at pH 8.0 for slides to be stained with IRS-2. The slides were stained on the Dako Autostainer (Dako Corporation, Carpinteria, CA) using EnVision+ (Dako) staining reagents. After an application of Dual Endogenous Block (Dako), followed by a buffer wash, the sections were incubated with rabbit polyclonal IRS-1 (cat. # sc-559, Santa Cruz, Santa Cruz CA) at a concentration of 1:400 and rabbit monoclonal IRS-2 (cat. # EP976Y, Epitomics, Burlingame CA) at a concentration of 1:400. Following a buffer wash, sections were then incubated with the EnVision+ Dual Link (Dako) detection reagent linked to horseradish peroxidase. The sections were then washed and treated with a solution of diaminobenzidine and hydrogen peroxide (DAB, Dako). After rinsing, a toning solution (DAB Enhancer, Dako) was used to enrich the final color. The sections were counterstained with hematoxylin, dehydrated, and coverslipped with permanent media.
Figure 1.Nuclear staining pattern for IRS-1. (IRS-1 immunohistochemical stain, 200x magnification)
Figure 2.Diffuse cytoplasmic staining pattern for IRS-2. (IRS-2 immunohistochemical stain, 200x magnification)
We used the following histologic criteria for IRS-1 and IRS-2 staining patterns which are outlined in a previous study.13 For IRS-1, a nuclear pattern was defined as diffuse nuclear staining (Figure 1). IRS-2 staining patterns were defined using the following criteria: Diffuse cytoplasmic staining was defined as evenly distributed cytoplasmic reactivity (Figure 2); punctate cytoplasmic staining was defined as clearly demarcated puncta of staining within the cytoplasm (Figure 3); and membrane staining was defined as focal or diffuse membranous staining (Figure 4). Sections of normal pancreas and normal breast tissue were used for positive and negative controls. The pathologists assessing staining patterns were blinded to the tumor recurrence score and all other data at the time of assessment.
Figure 3.Punctate cytoplasmic staining pattern for IRS-2. (IRS-2 immunohistochemical stain, 200x magnification)
Figure 4.Membranous staining pattern for IRS-2. (IRS-2 immunohistochemical stain, 200x magnification)
Imaging
Light microscopy was performed using a Nikon Eclipse E400 microscope (Nikon Inc.,Melville, NY). Photomicrographs were obtained using a SPOT Insight Color Model 3.2.0 microscope camera with SPOT Basic 5.1 imaging software (SPOT Imaging Solutions, Diagnostic Instruments Inc., Sterling Heights, MI).
Statistical Analysis
Statistical correlation for IRS-1 and recurrence score was done using contingency analysis and t-test; and correlation for IRS-2 and recurrence score was done using contingency analysis and one-way analysis of variance (ANOVA). The REMARK criteria were used for this study.20
Results
From the pathology archives, 123 cases were identified and stratified according to Oncotype DX recurrence score (low, intermediate, or high). Of those, 26 cases were excluded due to missing blocks or no tumor present in blocks examined. Of the remaining 97 cases, 12 cases had high recurrence scores, 30 with intermediate recurrence scores, and 55 with low recurrence scores. Follow-up data ranging from 3-6 years was acquired for these cases through the institutional tumor data registry, as well as medical records. Tumor characteristics for each case used in the study are summarized in Table 1.
Table 1. Tumor characteristics (n=97)| Total | ¹ IDC: invasive ductal carcinoma, ILC: invasive lobular carcinoma, IMC: invasive mammary carcinoma ² 1: Modified Bloom-Richardson (Nottingham) Score 3-5 = Grade 1; Score 6,7 = Grade 2; Score 8,9 = Grade 3 ³ ER/PR score: 1 = 1-10% cells positive; 2 = 11-25% cells positive; 3 = 26-75% cells positive; 4 = >75% cells positive.4 Her2 score: Her2 evaluated using ASCO-CAP guidelines. FISH was performed on 24 cases, all of which were negative for over-expression. | ||||||
| Oncotype DX RS, no. (%) | |||||||
| Low (0-17) | 55 (56.7) | ||||||
| Intermediate (18-30) | 30 (30.9) | ||||||
| High (>30) | 12 (12.4) | ||||||
| Mean Oncotype DX RS | 19 | ||||||
| Oncotype DX Recurrence Score | |||||||
| Low | Intermediate | High | |||||
| Age (years), no. (%) | |||||||
| ≤50 | 35 (36.1) | 19 (34.5) | 12 (40.0) | 4 (33.3) | |||
| >50 | 62 (63.9) | 36 (65.5) | 18 (60.0) | 8 (67.7) | |||
| Median age (years) | 55 | 56 | 53.5 | 54.5 | |||
| Diagnosis ¹ , no. (%) | |||||||
| IDC | 74 (76.3) | 38 (69.1) | 25 (83.3) | 11 (91.7) | |||
| ILC | 18 (18.6) | 13 (23.6) | 5 (16.7) | 0 (0.0) | |||
| IDC,ILC | 3 (3.1) | 2 (3.6) | 0 (0.0) | 1 (8.3) | |||
| IMC | 2 (2.0) | 2 (3.6) | 0 (0.0) | 0 (0.0) | |||
| Tumor size, no. (%) | |||||||
| ≤2cm | 83 (85.6) | 48 (87.3) | 25 (83.3) | 10 (83.3) | |||
| >2cm to ≤5cm | 13 (13.4) | 6 (10.9) | 5 (16.7) | 2 (16.7) | |||
| >5cm | 1 (1.0) | 1 (1.8) | 0 (0.0) | 0 (0.0) | |||
| Tumor grade ² , no. (%) | |||||||
| 1 | 27 (27.8) | 20 (36.4) | 7 (23.3) | 0 (0.0) | |||
| 2 | 59 (60.8) | 32 (58.2) | 17 (56.7) | 10 (83.3) | |||
| 3 | 11 (11.4) | 3 (5.4) | 6 (20.0) | 2 (16.7) | |||
| Nodes, no. (%) | |||||||
| 1 positive | 2 (2.0) | 2 (3.6) | 0 (0.0) | 0 (0.0) | |||
| 0 positive | 87 (89.7) | 49 (89.1) | 27 (90.0) | 11 (91.7) | |||
| Unknown | 8 (8.3) | 4 (7.3) | 3 (10.0) | 1 (8.3) | |||
| ER score ³ , no. (%) | |||||||
| 1 | 7 (7.2) | 3 (5.45) | 1 (3.3) | 3 (25.0) | |||
| 2 | 0 (0.0) | 0 (0.0) | 0 (0.0) | 0 (0.0) | |||
| 3 | 8 (8.3) | 3 (5.45) | 3 (10.0) | 2 (16.7) | |||
| 4 | 82 (84.5) | 49 (89.1) | 26 (86.7) | 7 (58.3) | |||
| PR score ³ , no. (%) | |||||||
| 1 | 24 (24.7) | 8 (14.6) | 8 (26.7) | 8 (66.7) | |||
| 2 | 5 (5.2) | 3 (5.4) | 1 (3.3) | 1 (8.3) | |||
| 3 | 26 (26.8) | 16 (29.1) | 8 (26.7) | 2 (16.7) | |||
| 4 | 42 (43.3) | 28 (50.9) | 13 (43.3) | 1 (8.3) | |||
| Her2 score 4 , no. (%) | |||||||
| 0 | 28 (28.9) | 23 (41.8) | 3 (10.0) | 2 (16.6) | |||
| ≤1 | 32 (33.0) | 17 (30.9) | 10 (33.3) | 5 (41.7) | |||
| >1 | 37 (38.1) | 15 (27.3) | 17 (56.7) | 5 (41.7) | |||
The distribution of IRS-1 and IRS-2 staining patterns amongst the RS groups is summarized in Table 2. IRS-1 exhibited nuclear staining in 5 of 12 (41.7%) tumors with high RS, 19 of 30 (63.3%) tumors with intermediate RS, and 23 of 55 (41.8%) tumors with low RS. All other tumors exhibited negative staining for IRS-1. Nuclear IRS-1 expression did not significantly correlate with RS (contingency analysis (P=.1436), t-test (P=.5654)).
Table 2. IRS-1 and IRS-2 correlation with Oncotype DX Recurrence Scores (RS)| Staining Pattern | High RS, no. (%) | Intermediate RS, no. (%) | Low RS, no. (%) | P-value* | |
| IRS-1 | Nuclear Staining | 5 (41.7) | 19 (63.3) | 23 (41.8) | .1436 |
| Negative | 7 (58.3) | 11 (36.6) | 32 (58.2) | ||
| IRS-2 | Diffuse Pattern | 5 (41.7) | 5 (16.7) | 11 (21.7) | .0371 |
| Membranous Pattern | 3 (25) | 2 (6.7) | 5 (9.1) | ||
| Punctate Pattern | 3 (25) | 17 (56.7) | 37 (67.3) | ||
| Negative | 1 (8.3) | 6 (19.9) | 2 (1.9) |
Contingency analysis
Overall, 21 of 97 (21.7%) cases exhibited diffuse expression of IRS-2, 10 of 97 (10.3%) exhibited membrane expression, 57 of 97 (58.8%) exhibited punctate expression, and 9 of 97 (9.3%) were negative for IRS-2. Among tumors with high RS, the most common pattern was diffuse in 5 of 12 (41.7%) cases, while tumors with intermediate and low RS were more likely to exhibit punctate expression of IRS-2 (17 of 30 (56.7%) and 37 of 55 (67.3%), respectively). IRS-2 expression patterns however, did correlate significantly with RS. On contingency analysis, the distribution of diffuse, membrane, punctate, and negative staining patterns for IRS-2 among high, intermediate, and low RS groups was statistically significant (P=.0371). One-way ANOVA also demonstrated a significant difference in the distribution of staining patterns for IRS-2 amongst the three RS groups (P=.045). When punctate expression of IRS-2 was compared to all other expression patterns, the distribution among RS was also statistically significant (contingency analysis (P=.010), one-way ANOVA (P=.023)), with punctate expression correlating with lower RS (low and intermediate risk). Interestingly, simply comparing positive versus negative IRS-2 expression amongst RS groups did not demonstrate statistical significance (contingency analysis (P=.054), t-test (P=.700)).
There were five deaths during the follow-up period due to causes unrelated to the original breast cancer diagnosis. Two of these patients had developed a second breast cancer. Nine patients developed recurrent or progressive disease. Only one had a high RS, and this patient exhibited IRS-2 expression at the cell membrane. Of the remaining 8 patients; 5 had intermediate RS (3 with punctate staining, 1 with diffuse staining and 1 with membranous staining) and 3 had low RS (2 with punctate staining and 1 with diffuse staining). The very low number of patients with significant follow-up precluded the achievement of statistical significance.
Discussion
We present the first report of IRS expression patterns in relation to Oncotype DX in ER+ early breast cancer. IRS-1 expression, which was predominantly nuclear when present, did not correlate to RS. However, we did find a significant association between IRS-2 expression patterns and RS. Consistent with a previous study from our group demonstrating a poor prognosis in the setting of IRS-2 expression at the cell membrane, the membrane pattern was least likely to be seen in the low RS group.13 Unfortunately, due to a very low number of cases with high RS in our study, it is not possible to determine if the high RS group is more likely to demonstrate membrane expression, as expected based on our prior study.13 We conclude that IRS-2 expression patterns used in conjunction with Oncotype DX scores may be useful in predicting prognosis, pending larger studies.
It is not surprising that IRS-1 expression was not a significant factor in this study population. IRS-1 expression is estrogen-regulated and more highly expressed in well-differentiated ER+ tumors with lower rates of recurrence, which encompasses the majority of our study population.21,22,23,24,25,26 The high rates of IRS-1 negativity in this study are not surprising either, given a previous study showing highly variable nuclear and cytoplasmic expression of IRS-1 in invasive ductal carcinoma.27 This suggests that the level of IRS-1 expression may fall on a spectrum, and further studies might further elucidate how expression levels, rather than cellular localization, correlate with disease progression, perhaps in the setting of intermediate RS where overall prognosis is unclear.
While a prior study demonstrated a role for membrane expression of IRS-2 in disease progression, this expression pattern was relatively rare in our study.13 There are two likely explanations for this finding. First, this study focused on cases with ER positivity, the population for which Oncotype DX is used in clinical practice, and ER activity upregulates PR expression.28 Our previous study demonstrated that membrane expression of IRS-2 was statistically more likely in the setting of PR negativity, and so it is unlikely to occur in a predominantly hormone receptor positive study population.13 Second, there were relatively few high RS cases in this study, which based on our previous study, is the subgroup expected to have the highest rates of IRS-2 expression at the cell membrane.13
The high rate of punctate IRS-2 expression in our study was also unexpected. Previous work demonstrated that there was no significant relationship between the punctate expression pattern, hormone receptor status, or clinical outcomes.13 Electron microscopy could be used to determine the specific sub-cellular localization responsible for this expression pattern, and a larger study might explore this expression pattern in the setting of intermediate RS where it could potentially have more prognostic value than in the population as a whole. The diffuse pattern was also found more frequently than expected, likely due to the high rate of hormone receptor positivity in this study, as this pattern is more likely to be seen in hormone receptor positive tumors with a relatively better prognosis.13
Work from our group and others has shown a role for IRS-2 in breast carcinoma cell motility and invasion, both markers of aggressive disease.2,8,11,29,30 Similarly, several genes included in the Oncotype DX assay have also been associated with invasiveness and tumor progression, including CD68, stromolysin 3, and cathepsin L2.31, 32, 33 IRS-2 expression in certain subtypes of breast cancer might have prognostic value as well. In combination with Oncotype DX recurrence scores, we would expect even higher statistical power to predict recurrence for individual patients. For example, in a study using both Oncotype DX scores and Adjuvant!Online scores, the combination was more predictive of actual outcomes than either score alone.34
Conclusion
In summary, we have shown for the first time that IRS-2 expression patterns in ER+ breast carcinoma correlate with Oncotype DX recurrence scores. In particular, membrane expression thought to be associated with worse outcome was least likely to be observed in the low RS group. Larger studies utilizing more cases with high RS and longer follow-up times are required to determine how IRS-2 expression might be used in conjunction with Oncotype DX recurrence scores to better predict outcomes and guide appropriate treatment. It might also give beneficial prognostic information in clinical settings where Oncotype DX testing is unavailable.
Acknowledgements
The first two authors contributed equally to the preparation of this manuscript. This work was supported in part by National Institute of Health (NIH) grant CA142782 (LMS).
References
- 1.Shaw L M. (2001) Identification of insulin receptor substrate 1 (IRS-1) and IRS-2 as signaling intermediates in the alpha6beta4 integrin-dependent activation of phosphoinositide 3-OH kinase and promotion of invasion.MolCellBiol,21(15):. 5082-93.
- 2.Gibson S L, ZMa L M, Shaw. (2007) . Divergent roles for IRS-1 and IRS-2 in breast cancer metastasis.Cell Cycle.6(6): 631-7.
- 3.Mardilovich K, Pankratz S L, Shaw L M. (2009) Expression and function of the insulin receptor substrate proteins in cancer.CellCommunSignal,7:. 14.
- 4.B C Turner. (1997) Insulin-like growth factor-I receptor overexpression mediates cellular radioresistance and local breast cancer recurrence after lumpectomy and radiation.Cancer Res,57(15):. 3079-83.
- 5.J L Resnik. (1998) Elevated insulin-like growth factor I receptor autophosphorylation and kinase activity in human breast cancer.Cancer Res.58(6):. 1159-64.
- 6.M E Patti. (1995) 4PS/insulin receptor substrate (IRS)-2 is the alternative substrate of the insulin receptor in IRS-1-deficient mice.JBiolChem,270(42):. 24670-3.
- 7.M F White. (1996) The IRS-signalling system in insulin and cytokine action.PhilosTrans RSocLondBBiolSci,351(1336):. 181-9.
- 8.S A Byron. (2006) Insulin receptor substrates mediate distinct biological responses to insulin-like growth factor receptor activation in breast cancer cells.BrJ.Cancer.95(9):. 1220-8.
- 9.Ma Z. (2006) Suppression of insulin receptor substrate 1 (IRS-1) promotes mammary tumor metastasis.MolCellBiol,26(24):. 9338-51.
- 10.S L Pankratz. (2009) Insulin receptor substrate-2 regulates aerobic glycolysis in mouse mammary tumor cells via glucose transporter 1.JBiolChem,284(4):. 2031-7.
- 11.J A Nagle. (2004) Involvement of insulin receptor substrate 2 in mammary tumor metastasis.MolCell Biol.24(22):. 9726-35.
- 12.Jackson J G.Regulation of breast cancer cell motility by insulin receptor substrate-2 (IRS-2) in metastatic variants of human breast cancer cell lines.Oncogene,20(50):. 7318-25.
- 13.J L Clark.Membrane localization of insulin receptor substrate-2 (IRS-2) is associated with decreased overall survival in breast cancer.Breast. , Cancer Res Treat 130(3), 759-72.
- 14.Paik S. (2004) A multigene assay to predict recurrence of tamoxifen-treated, node-negative breast cancer.NEnglJ Med,351(27):. 2817-26.
- 15.Paik S. (2006) Gene expression and benefit of chemotherapy in women with node-negative, estrogen receptor-positive breast cancer.JClinOncol.24(23):. 3726-34.
- 17.D J Williams. (2011) . Proliferation (Ki-67 and phosphohistone H3) and oncotype DX recurrence score in estrogen receptor-positive breast cancer.ApplImmunohistochemMolMorphol,19(5): 431-6.
- 18.Zbytek B. (2013) Nottingham-defined mitotic score: comparison with visual and image cytometric phosphohistone H3 labeling indices and correlation with Oncotype DX recurrence score.ApplImmunohistochemMolMorphol,21(1):. 48-53.
- 19.M E Klein.et al.,(2013). Prediction of the Oncotype DX recurrence score: use of pathology-generated equations derived by linear regression analysis.ModPathol,26(5):. 658-64.
- 20.L M McShane. (2006) REporting recommendations for tumor MARKer prognostic studies (REMARK). Breast Cancer Res Treat,100(2):. 229-35.
- 21.Koda M. (2005) Expression of insulin receptor substrate 1 in primary breast cancer and lymph node metastases.JClinPathol,58(6):. 645-9.
- 22.A V Lee. (1999) Enhancement of insulin-like growth factor signaling in human breast cancer: estrogen regulation of insulin receptor substrate-1 expression in vitro and in vivo.MolEndocrinol,13(5):. 787-96.
- 23.Mauro L. (2001) Estradiol increases IRS-1 gene expression and insulin signaling in breast cancer cells.BiochemBiophysResCommun,288(3):. 685-9.
- 24.Molloy C A, May F E, Westley B R. (2000) Insulin receptor substrate-1 expression is regulated by estrogen in the MCF-7 human breast cancer cell line.JBiolChem,275(17):. 12565-71.
- 25.Schnarr B. (2000) Down-regulation of insulin-like growth factor-I receptor and insulin receptor substrate-1 expression in advanced human breast cancer.IntJ Cancer,89(6) :. 506-13.
- 26.Sisci D. (2007) Expression of nuclear insulin receptor substrate 1 in breast cancer.JClinPathol,60(6):. 633-41.
- 27.Migliaccio I. (2010) Nuclear IRS-1 predicts tamoxifen response in patients with early breast cancer.Breast Cancer Res Treat,123(3):. 651-60.
- 28.Clarke R B, Howell A, Anderson E. (1997) Estrogen sensitivity of normal human breast tissue in vivo and implanted into athymic nude mice: analysis of the relationship between estrogen-induced proliferation and progesterone receptor expression.Breast Cancer Res Treat,45(2):. 121-33.
- 29.Y H Ibrahim. (2008) Progesterone receptor-B regulation of insulin-like growth factor-stimulated cell migration in breast cancer cells via insulin receptor substrate-2.MolCancer Res,6(9):. 1491-8.
- 30.Zhang X. (2004) Motility response to insulin-like growth factor-I (IGF-I) in MCF-7 cells is associated with IRS-2 activation and integrin expression. Breast Cancer Res Treat,83(2):. 161-70.
- 31.Eiro N. (2012) Impact of CD68/(CD3+CD20) ratio at the invasive front of primary tumors on distant metastasis development in breast cancer.PLoSOne,7(12):. 52796.
- 32.Basset P, Wolf C, Chambon P. (1993) Expression of the stromelysin-3 gene in fibroblastic cells of invasive carcinomas of the breast and other human tissues: a review.Breast Cancer Res Treat,24(3):. 185-93.
Cited by (1)
This article has been cited by 1 scholarly work according to:
Citing Articles:
Journal of Cancer Genetics and Biomarkers (2014) OpenAlex
